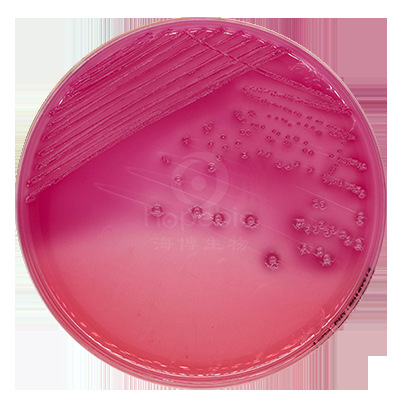
麦康凯琼脂平板(9cm) hbpm016 10个/包 青岛海博生物

血琼脂平板图片

血平板 血平皿 血琼脂平板 哥伦比亚血平板 9cm
图片尺寸253x300
血琼脂平板
图片尺寸1500x1500
血琼脂平板
图片尺寸2771x2174
cp0210环凯微生物四号琼脂平板90mm20个盒
图片尺寸1920x2090
琼脂平板.jpg
图片尺寸800x535
琼脂平板火锅底料版
图片尺寸1080x1439
029980 palcam琼脂平板 即用成品 90mm-广东环凯生物科技有限公司-bhk
图片尺寸2234x2441
哥伦比亚血琼脂平板tsa琼脂平板血平板培养基营养计数琼脂平板9cm
图片尺寸800x800
麦康凯琼脂平板(9cm) hbpm016 10个/包 青岛海博生物
图片尺寸400x400
xlt4琼脂大肠埃希氏菌xlt4琼脂鼠伤寒沙门氏菌xlt4琼脂福氏志贺氏菌
图片尺寸750x750
ss琼脂平板9cm
图片尺寸3460x3460
海博生物 营养琼脂平板(9cm),hbpm003-6,10个/包,细菌计数,不含糖,可
图片尺寸697x632
胰酪胨大豆羊血(tssb)琼脂平板
图片尺寸1293x1280
四号琼脂平板
图片尺寸573x573
幽门螺杆菌琼脂平板
图片尺寸650x434
标签:河南哥伦比亚血琼脂平板供应商
图片尺寸500x305
营养琼脂平板
图片尺寸2848x1728
伊红美蓝琼脂平板9cm 青岛海博生物 hbpm007
图片尺寸400x400
cin1琼脂平板9cm青岛海博生物hbpm033
图片尺寸500x500
金黄色葡萄球菌 (哥伦比亚血琼脂平板)
图片尺寸583x557